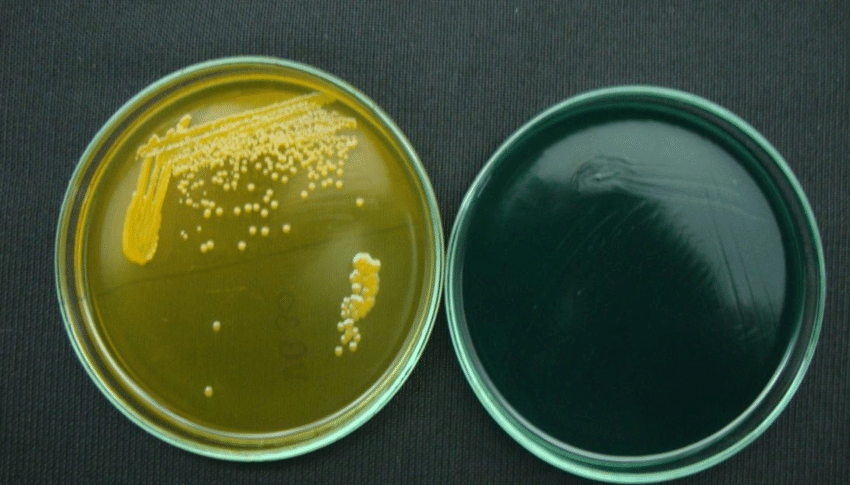

膽酸鈉可用于防止膽石生成,還可用于消炎,非變性去垢劑用于抽提膜蛋白作為生化研究試劑;用于配制細菌培養(yǎng)基。西寶生物專業(yè)提供膽酸鈉Sodium Cholate (CAS: 361-09-1),服務(wù)熱線:400-021-8158。

TCBS瓊脂培養(yǎng)基,用于致病性弧菌(霍亂、副溶血性弧菌)的選擇性分離培養(yǎng)(GB2008、SN標(biāo)準(zhǔn))。組成成分:酵母粉 5.0 , 蛋白胨10.0, 硫代硫酸鈉10.0, 枸櫞酸鈉10.0, 牛膽粉5.0, 牛膽酸鈉3.0 , 蔗糖20.0 , 氯化鈉10.0, 檸檬酸鐵1.0 , 麝香草酚蘭0.04, 瓊脂15.0, pH值8.6 ± 0.1,保存溫度25℃。膽酸鈉、牛膽粉、硫代硫酸鈉和檸檬酸鈉及較高的pH可抑制革蘭氏陽性菌和大腸菌群;霍亂弧菌對酸性環(huán)境比較敏感,因此該pH值可增強其生長;硫代硫酸鈉與檸檬酸鐵反應(yīng)作為檢測硫化氫產(chǎn)生的指示劑;溴麝香草酚蘭和麝香草酚蘭是pH指示劑;瓊脂是培養(yǎng)基的凝固劑。
產(chǎn)品名稱: | 膽酸鈉 |
英文名稱: | Sodium Cholate |
別名: | 361-09-1 |
CAS: | 膽汁酸,水合膽酸鈉 |
結(jié)構(gòu)式: |
|
膽酸鈉質(zhì)量指標(biāo)
Purity | >98.5% |
pH value(50g/l, H2O, 20℃) | 8.0~10.0 |
Loss on drying (105℃;3h) | ≤5.0% |
TLC-Test | passes test |
Desoxycholic acid(TLC) | ≤0.5% |
Sulfated ash(600℃) | 15.8~17.0% |
Heavy Metals(as Pb) | ≤0.001% |
Appearance | White powder |
膽酸鈉可用于防止膽石生成,還可用于消炎,非變性去垢劑用于抽提膜蛋白作為生化研究試劑;用于配制細菌培養(yǎng)基。西寶生物專業(yè)提供膽酸鈉Sodium Cholate (CAS: 361-09-1),服務(wù)熱線:400-021-8158。
TCBS瓊脂培養(yǎng)基,用于致病性弧菌(霍亂、副溶血性弧菌)的選擇性分離培養(yǎng)(GB2008、SN標(biāo)準(zhǔn))。組成成分:酵母粉 5.0 , 蛋白胨10.0, 硫代硫酸鈉10.0, 枸櫞酸鈉10.0, 牛膽粉5.0, 牛膽酸鈉3.0 , 蔗糖20.0 , 氯化鈉10.0, 檸檬酸鐵1.0 , 麝香草酚蘭0.04, 瓊脂15.0, pH值8.6 ± 0.1,保存溫度25℃。膽酸鈉、牛膽粉、硫代硫酸鈉和檸檬酸鈉及較高的pH可抑制革蘭氏陽性菌和大腸菌群;霍亂弧菌對酸性環(huán)境比較敏感,因此該pH值可增強其生長;硫代硫酸鈉與檸檬酸鐵反應(yīng)作為檢測硫化氫產(chǎn)生的指示劑;溴麝香草酚蘭和麝香草酚蘭是pH指示劑;瓊脂是培養(yǎng)基的凝固劑。
產(chǎn)品名稱: | 膽酸鈉 |
英文名稱: | Sodium Cholate |
別名: | 361-09-1 |
CAS: | 膽汁酸,水合膽酸鈉 |
結(jié)構(gòu)式: |
|
膽酸鈉質(zhì)量指標(biāo)
Purity | >98.5% |
pH value(50g/l, H2O, 20℃) | 8.0~10.0 |
Loss on drying (105℃;3h) | ≤5.0% |
TLC-Test | passes test |
Desoxycholic acid(TLC) | ≤0.5% |
Sulfated ash(600℃) | 15.8~17.0% |
Heavy Metals(as Pb) | ≤0.001% |
Appearance | White powder |



